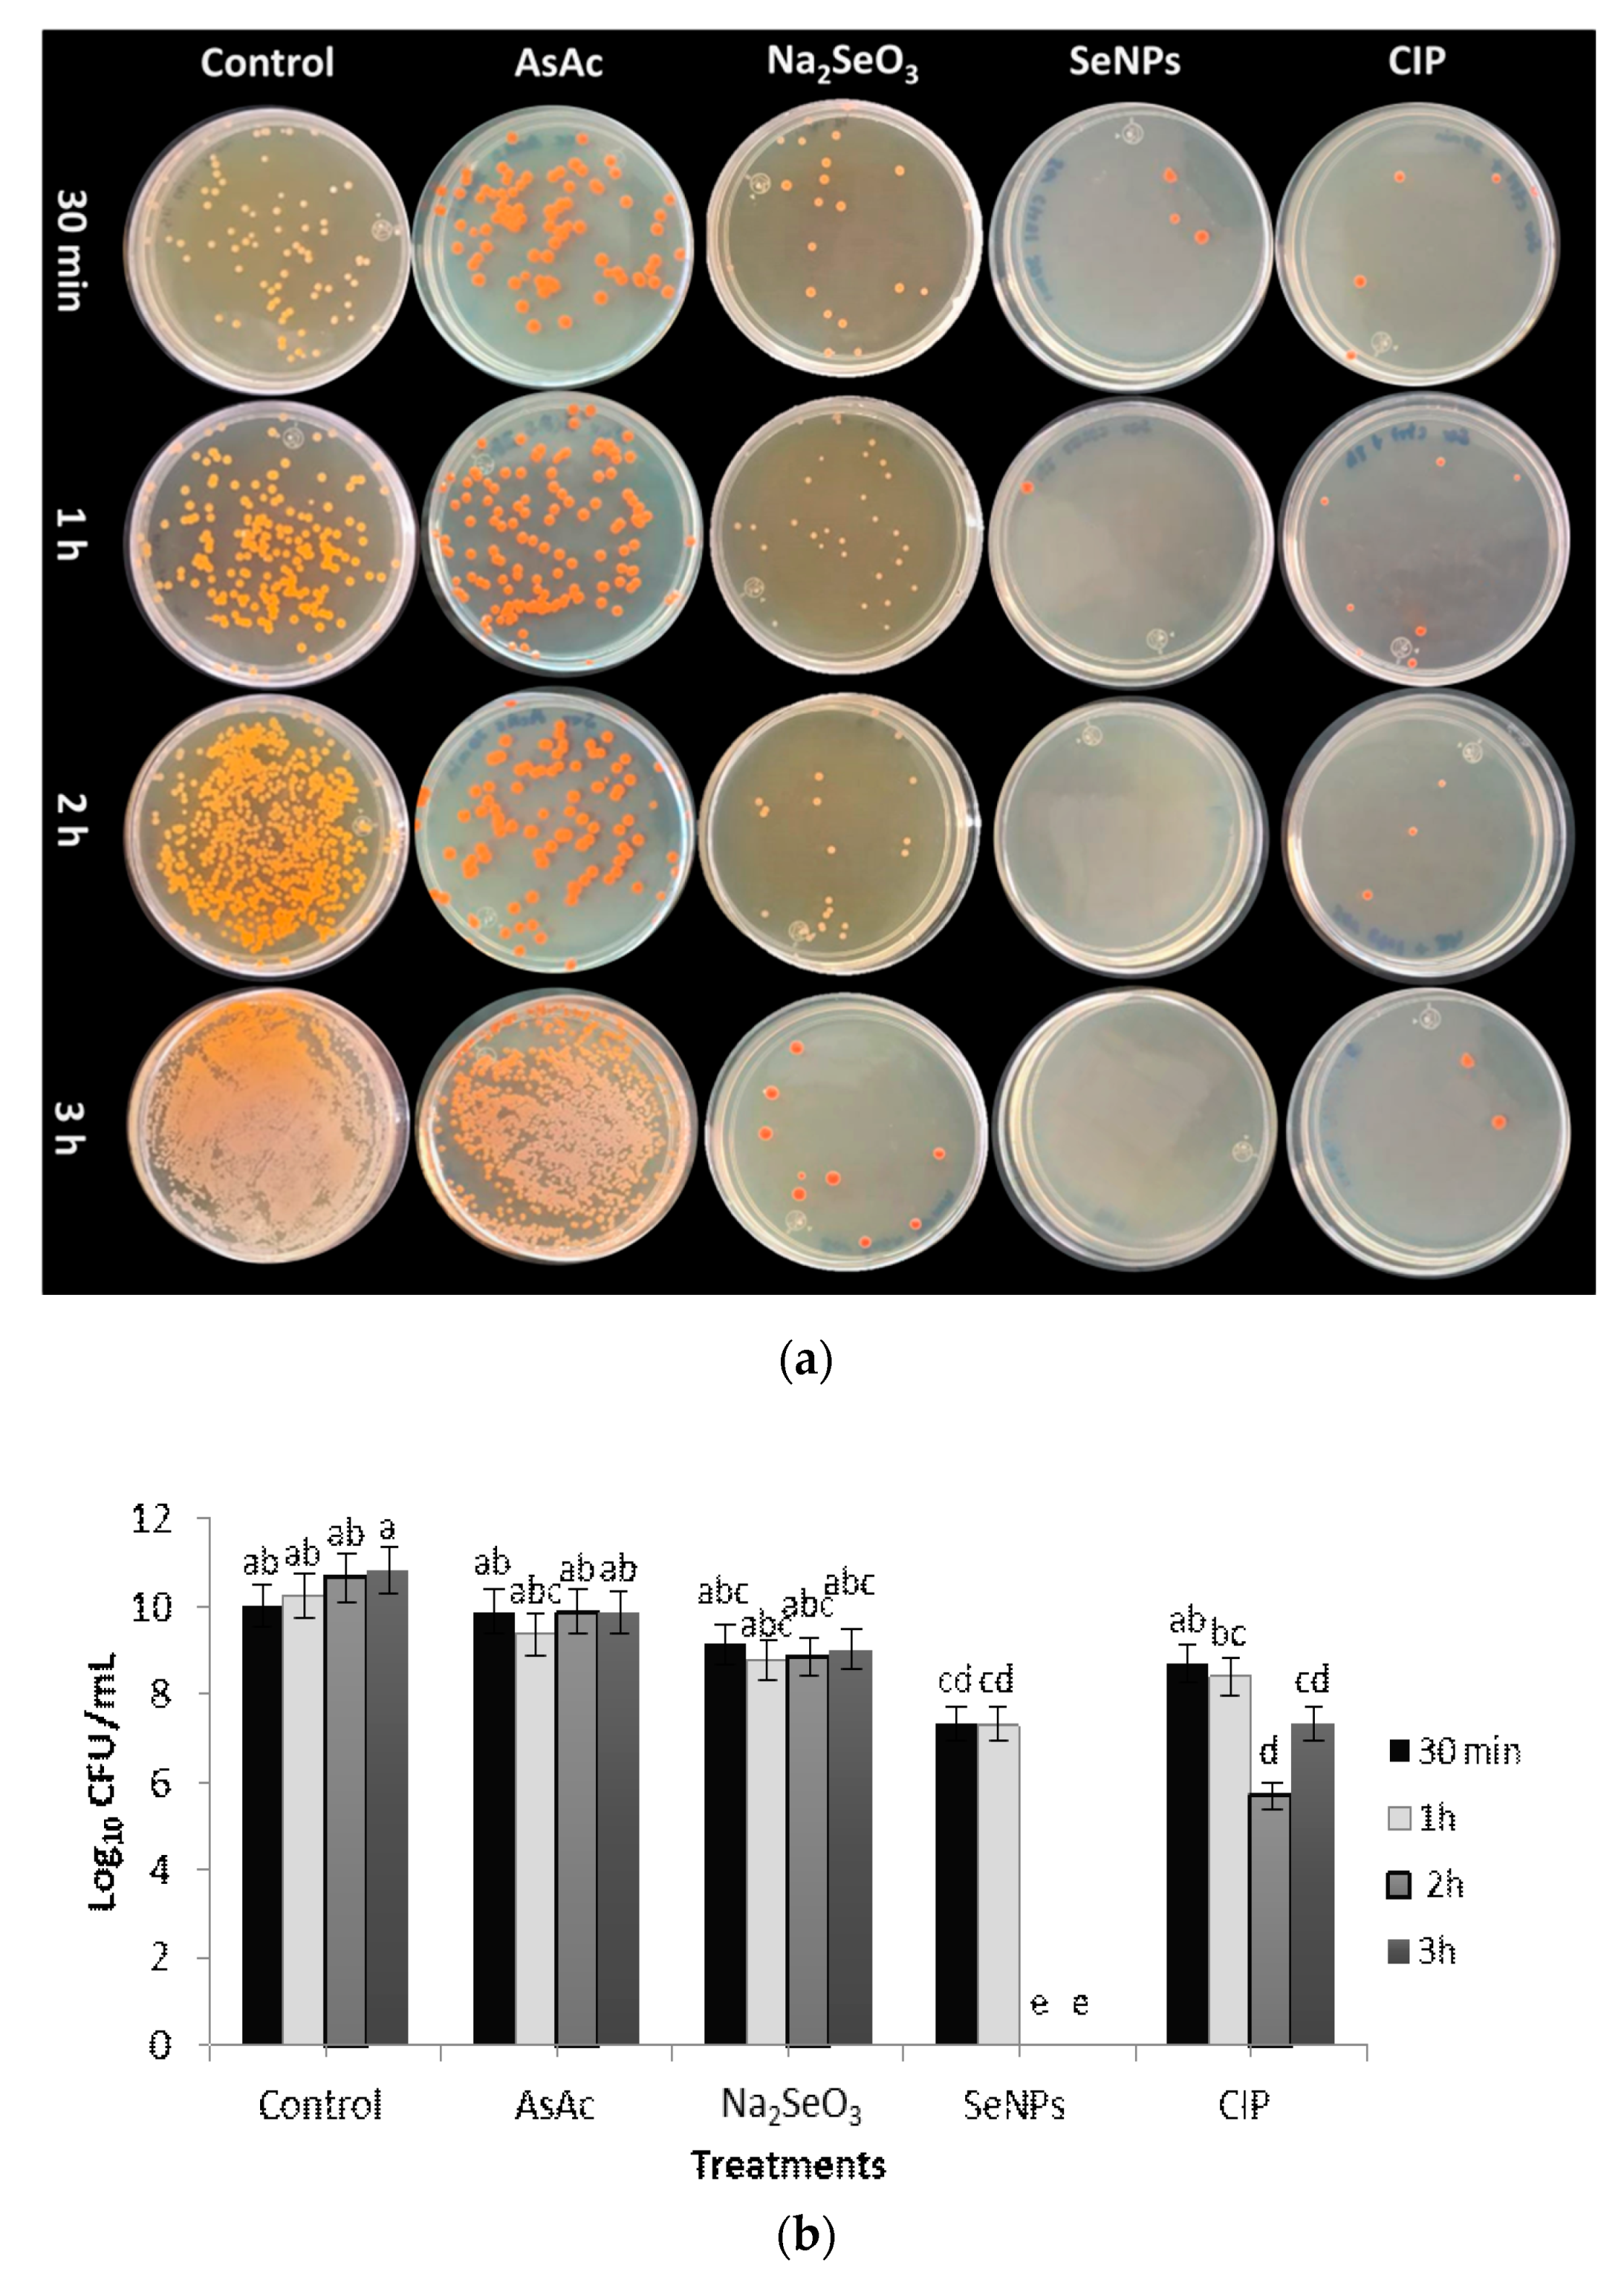

Antibacterial Activity of Biosynthesized Selenium Nanoparticles Using Extracts of Calendula officinalis against Potentially Clinical Bacterial Strains
Abstract
:1. Introduction
2. Results and Discussion
2.1. Antibacterial Activity of Plant Extracts
2.2. Green Synthesis and Characterization of SeNPs
2.3. Antibacterial Activity of SeNPs
2.4. Antioxidant Activity of SeNPs
3. Materials and Methods
3.1. Plant Material Production
3.2. Preparation of Plant Extracts and Their Fractions
3.3. Obtaining and Characterization of Bacterial Strains
3.4. Evaluation of the Antibacterial Activity of Plant Extracts and Their Fractions
3.5. SeNPs Synthesis
3.6. SeNPs Characterization
3.7. Evaluation of the Antibacterial Activity of SeNPs
3.8. Antioxidant Activity Evaluation of SeNPs
3.9. Statistical Analysis
4. Conclusions
Author Contributions
Funding
Acknowledgments
Conflicts of Interest
Sample Availability
References
- Bayda, S.; Adeel, M.; Tuccinardi, T.; Cordani, M.; Rizzolio, F. The History of nanoscience and nanotechnology: From chemical-physical applications to nanomedicine. Molecules 2019, 25, 112. [Google Scholar] [CrossRef] [PubMed] [Green Version]
- Pelyhe, C.; Mézes, M. Myths and facts about the effects of nano-selenium in farm animals mini-review. Eur. Chem. Bull. 2013, 2, 1049–1052. [Google Scholar]
- Moghimi, S.M.; Hunter, A.C.; Murray, J.C. Nanomedicine: Current status and future prospects. FASEB J. 2005, 19, 311–330. [Google Scholar] [CrossRef] [PubMed] [Green Version]
- Patra, J.K.; Das, G.; Fraceto, L.F.; Campos, E.; Rodriguez-Torres, M.; Acosta-Torres, L.S.; Diaz-Torres, L.A.; Grillo, R.; Swamy, M.K.; Sharma, S.; et al. Nano based drug delivery systems: Recent developments and future prospects. J. Nanobiotechnol. 2018, 16, 71. [Google Scholar] [CrossRef] [Green Version]
- Garza-García, J.J.O.; Hernández-Díaz, J.A.; Zamudio-Ojeda, A.; León-Morales, J.M.; Guerrero-Guzmán, A.; Sánchez-Chiprés, D.R.; López-Velázquez, J.C.; García-Morales, S. The role of selenium nanoparticles in agriculture and food technology. Biol. Trace Elem. Res. 2021. [Google Scholar] [CrossRef]
- Rayman, M.P. The importance of selenium to human health. Lancet. 2000, 365, 233–241. [Google Scholar] [CrossRef] [Green Version]
- Khurana, S.; Tekula, M.A.; Saifi, P.; Venkatesh, P.; Godugu, C. Therapeutic applications of selenium nanoparticle. Biomed. Pharmacother. 2019, 111, 802–812. [Google Scholar] [CrossRef] [PubMed]
- Ikram, M.; Javed, B.; Raja, N.I.; Mashwani, Z.U. Biomedical potential of plant-based selenium nanoparticles: A comprehensive review on therapeutic and mechanistic aspects. Int. J. Nanomed. 2021, 16, 249–268. [Google Scholar] [CrossRef] [PubMed]
- Efstratiou, E.; Hussain, A.I.; Nigam, P.S.; Moore, J.E.; Ayub, M.A.; Rao, J.R. Antimicrobial activity of Calendula officinalis petal extracts against fungi, as well as Gram-negative and Gram-positive clinical pathogens. Complement. Ther. Clin. Pract. 2012, 18, 173–176. [Google Scholar] [CrossRef]
- Ram, S.; Mitra, M.; Shah, F.; Tirkey, S.R.; Mishra, S. Bacteria as an alternate biofactory for carotenoid production: A review of its applications, opportunities and challenges. J. Funct. Foods. 2020, 67, 103867. [Google Scholar] [CrossRef]
- Olfati, A.; Kahrizi, D.; Jalal Balaky, S.T.; Rouhallah Sharifi, M.B.; ElahehDarvishi, T. Green synthesis of nanoparticles using Calendula officinalis extract from silver sulfate and their antibacterial effects on Pectobacterium caratovorum. Inorg. Chem. Commun. 2021, 125, 108439. [Google Scholar] [CrossRef]
- Nandini, B.; Hariprasad, P.; Prakash, H.S.; Shetty, H.S.; Geetha, N. Trichogenic-selenium nanoparticles enhance disease suppressive ability of Trichoderma against downy mildew disease caused by Sclerospora graminicola in pearl millet. Sci. Rep. 2017, 7, 2612. [Google Scholar] [CrossRef] [PubMed]
- Shahabadi, N.; Zendehcheshm, S.; Khademi, F. Selenium nanoparticles: Synthesis, in-vitro cytotoxicity, antioxidant activity and interaction studies with ct-DNA and HSA, HHb and Cyt c serum proteins. Biotechnol. Rep. 2021, 30, e00615. [Google Scholar] [CrossRef]
- Vahdati, M.; Tohidi Moghadam, T. Synthesis and characterization of selenium nanoparticles-lysozyme nanohybrid system with synergistic antibacterial properties. Sci. Rep. 2020, 10, 510. [Google Scholar] [CrossRef] [PubMed] [Green Version]
- Fierascu, I.; Bunghez, I.; Fierascu, C.R.; Ion, R.; Romania, B. Characterization and antioxidant activity of phytosynthesised silver nanoparticles using Calendula officinalis extract. Farmacia-Bucuresti. 2014, 62, 129–136. [Google Scholar]
- Fardsadegh, B.; Vaghari, H.; Mohammad-Jafari, R.; Najian, Y.; Jafarizadeh-Malmiri, H. Biosynthesis, characterization and antimicrobial activities assessment of fabricated selenium nanoparticles using Pelargonium zonale leaf extract. Green Process. Synth. 2019, 8, 191–198. [Google Scholar] [CrossRef]
- Filipović, N.; Ušjak, D.; Milenković, M.T.; Zheng, K.; Liverani, L.; Boccaccini, A.R.; Stevanović, M.M. Comparative study of the antimicrobial activity of selenium nanoparticles with different surface chemistry and structure. Front. Bioeng. Biotechnol. 2021, 8, 624621. [Google Scholar] [CrossRef]
- Dhanjal, S.; Cameotra, S. Aerobic biogenesis of selenium nanospheres by Bacillus cereus isolated from coalmine soil. Microb. Cell Factories 2010, 9, 52. [Google Scholar] [CrossRef] [Green Version]
- Asano, N.; Lu, J.; Asahina, S.; Takami, S. Direct observation techniques using scanning electron microscope for hydrothermally synthesized nanocrystals and nanoclusters. Nanomaterials 2021, 11, 908. [Google Scholar] [CrossRef]
- Qu, Y.; Yang, H.; Yang, N.; Fan, Y.; Zhu, H.; Zou, G. The effect of reaction temperature on the particle size, structure and magnetic properties of coprecipitated CoFe2O4 nanoparticles. Mater. Lett. 2006, 60, 3548–3552. [Google Scholar] [CrossRef]
- Ankamwar, B.; Damle, C.; Ahmad, A.; Sastry, M. Biosynthesis of gold and silver nanoparticles using Emblica Officinalis fruit extract, their phase transfer and transmetallation in an organic solution. J. Nanosci. Nanotechnol. 2005, 5, 1665–1671. [Google Scholar] [CrossRef]
- Cittrarasu, V.; Kaliannan, D.; Dharman, K.; Maluventhen, V.; Easwaran, M.; Liu, W.C.; Balasubramanian, B.; Arumugam, M. Green synthesis of selenium nanoparticles mediated from Ceropegia bulbosa Roxb extract and its cytotoxicity, antimicrobial, mosquitocidal and photocatalytic activities. Sci. Rep. 2021, 11, 1032. [Google Scholar] [CrossRef]
- Pirtarighat, S.; Ghannadnia, M.; Baghshahi, S. Green synthesis of silver nanoparticles using the plant extract of Salvia spinosa grown in vitro and their antibacterial activity assessment. J. Nanostruct. Chem. 2019, 9, 1–9. [Google Scholar] [CrossRef] [Green Version]
- Arockiya Aarthi Rajathi, F.; Arumugam, R.; Saravanan, S.; Anantharaman, P. Phytofabrication of gold nanoparticles assisted by leaves of Suaeda monoica and its free radical scavenging property. J. Photochem. Photobiol. B 2014, 135, 75–80. [Google Scholar] [CrossRef]
- Zhuang, J.; Li, M.; Pu, Y.; Ragauskas, A.J.; Yoo, C.G. Observation of potential contaminants in processed biomass using fourier transform infrared spectroscopy. Appl. Sci. 2020, 10, 4345. [Google Scholar] [CrossRef]
- Santhoshkumar, J.; Rajeshkumar, S.; Venkat Kumar, S. Phyto-assisted synthesis, characterization and applications of gold Nanoparticles—A review. Biochem. Biophys. Rep. 2017, 11, 46–57. [Google Scholar] [CrossRef]
- Kannan, S.; Mohanraj, K.; Prabhu, K.; Barathan, S.; Sivakumar, G. Synthesis of selenium nanorods with assistance of biomolecule. Bull. Mater. Sci. 2014, 37, 1631–1635. [Google Scholar] [CrossRef]
- Balashanmugam, P.; Pudupalayam, T.K. Biosynthesis characterization of silver nanoparticles using Cassia roxburghii DC. aqueous extract, and coated on cotton cloth for effective antibacterial activity. Int. J. Nanomed. 2015, 10, 87–97. [Google Scholar] [CrossRef] [PubMed] [Green Version]
- Stella, C.; Soundararajan, N.; Ramachandran, K. Structural, optical, and magnetic properties of Mn and Fe-doped Co3O4 nanoparticles. AIP Adv. 2015, 5, 087104. [Google Scholar] [CrossRef]
- Al Jahdaly, B.A.; Al-Radadi, N.S.; Eldin, G.M.G.; Almahri, A.; Ahmed, M.K.; Shoueir, K.; Janowska, I. Selenium nanoparticles synthesized using an eco-friendly method: Dye decolorization from aqueous solutions, cell viability, antioxidant, and antibacterial effectiveness. J. Mater. Res. Technol. 2021, 11, 85–97. [Google Scholar] [CrossRef]
- Saidin, S.; Jumat, M.A.; Mohd, A.; Nur, A.A.; Saleh, A.; Abdullah, S. Organic and inorganic antibacterial approaches in combating bacterial infection for biomedical application. Mater. Sci. Eng. C Mater. Biol. Appl. 2021, 118, 111382. [Google Scholar] [CrossRef]
- Kim, S.B.; Jeon, Y.D.; Kim, J.H.; Kim, J.K.; Ann, H.W.; Choi, H.; Kim, M.H.; Song, J.E.; Ahn, J.Y.; Jeong, S.J.; et al. Risk factors for mortality in patients with Serratia marcescens bacteremia. Yonsei Med, J. 2015, 56, 348–354. [Google Scholar] [CrossRef] [Green Version]
- Chiang, P.C.; Wu, T.L.; Kuo, A.J.; Huang, Y.C.; Chung, T.Y.; Lin, C.S.; Su, L.H. Outbreak of Serratia marcescens postsurgical bloodstream infection due to contaminated intravenous pain control fluids. Int. J. Infect. Dis. 2013, 17, e718–e722. [Google Scholar] [CrossRef] [PubMed] [Green Version]
- Jarvis, E.M.; Hawley, C.M.; McDonald, S.P.; Brown, F.G.; Rosman, J.B.; Wiggins, K.J.; Bannister, K.M.; Johnson, D.W. Predictors, treatment, and outcomes of non-Pseudomonas Gram-negative peritonitis. Kidney Int. 2010, 78, 408–414. [Google Scholar] [CrossRef] [PubMed]
- Menon, S.; Agarwal, H.; Rajeshkumar, S.; Jacquline, R.P.; Shanmugam, V.K. Investigating the antimicrobial activities of the biosynthesized selenium nanoparticles and its statistical analysis. Bionanoscience 2020, 10, 122–135. [Google Scholar] [CrossRef]
- Jeong, Y.; Lim, D.W.; Choi, J. Assessment of size-dependent antimicrobial and cytotoxic properties of silver nanoparticles. Adv. Mater. Sci. Eng. 2014, 2014, 763807. [Google Scholar] [CrossRef] [Green Version]
- Gunti, L.; Dass, R.S.; Kalagatur, N.K. Phytofabrication of selenium nanoparticles from Emblica officinalis fruit extract and exploring its biopotential applications: Antioxidant, antimicrobial, and biocompatibility. Front. Microbiol. 2019, 10, 931. [Google Scholar] [CrossRef] [Green Version]
- Bhave, P.; Tregaskis, P.; Walker, R.; Wilson, S. Intraperitoneal meropenem for peritoneal dialysis peritonitis with Serratia marcescens immediately on commencing dialysis. New Microbes New Infect. 2016, 10, 84–86. [Google Scholar] [CrossRef] [Green Version]
- Khanna, A.; Khanna, M.; Aggarwal, A. Serratia marcescens—A rare opportunistic nosocomial pathogen and measures to limit its spread in hospitalized patients. J. Clin. Diagn. Res. 2013, 7, 243–246. [Google Scholar]
- Ravindran, D.; Ramanathan, S.; Arunachalam, K.; Jeyaraj, G.P.; Shunmugiah, K.P.; Arumugam, V.R. Phytosynthesized silver nanoparticles as antiquorum sensing and antibiofilm agent against the nosocomial pathogen Serratia marcescens: An in vitro study. J. Appl. Microbiol. 2018, 124, 1425–1440. [Google Scholar] [CrossRef]
- Ghada, M.K.; Bahig, A.E. Antimicrobial and antibiofilm effects of selenium nanoparticles on some foodborne pathogens. LWT-Food Sci. Technol. 2015, 63, 1001–1007. [Google Scholar]
- Fernández, L.; Hancock, R.E. Adaptive and mutational resistance: Role of porins and efflux pumps in drug resistance. Clin. Microbiol. Rev. 2012, 25, 661–681. [Google Scholar] [CrossRef] [Green Version]
- Rudramurthy, G.; Swamy, M.; Sinniah, U.; Ghasemzadeh, A. Nanoparticles: Alternatives against drug-resistant pathogenic microbes. Molecules 2016, 21, 836. [Google Scholar] [CrossRef] [PubMed]
- Hernández-Díaz, J.A.; Garza-García, J.J.; Zamudio-Ojeda, A.; León-Morales, J.M.; López-Velázquez, J.C.; García-Morales, S. Plant-mediated synthesis of nanoparticles and their antimicrobial activity against phytopathogens. J. Sci. Food Agric. 2021, 101, 1270–1287. [Google Scholar] [CrossRef] [PubMed]
- Zawadzka, A.M.; Crawford, R.L.; Paszczynski, A.J. Pyridine-2,6-bis(thiocarboxylic acid) produced by Pseudomonas stutzeri KC reduces and precipitates selenium and tellurium oxyanions. Appl. Environ. Microbiol. 2006, 72, 3119–3129. [Google Scholar] [CrossRef] [PubMed] [Green Version]
- Xu, C.L.; Wang, Y.Z.; Jin, M.L.; Yang, X.Q. Preparation, characterization and immunomodulatory activity of selenium-enriched exopolysaccharide produced by bacterium Enterobacter cloacae Z0206. Bioresour. Technol. 2009, 100, 2095–2097. [Google Scholar] [CrossRef] [PubMed]
- Fernández-Llamosas, H.; Castro, L.; Blázquez, M.L.; Díaz, E.; Carmona, M. Biosynthesis of selenium nanoparticles by Azoarcus sp. CIB. Microb. Cell Fact. 2016, 15, 109. [Google Scholar] [CrossRef] [PubMed]
- Huang, C. Extensively drug-resistant Alcaligenes faecalis infection. BMC Infect. Dis. 2020, 20, 833. [Google Scholar] [CrossRef] [PubMed]
- Hasan, M.J.; Nizhu, L.N.; Rabbani, R. Bloodstream infection with pandrug-resistant Alcaligenes faecalis treated with double-dose of tigecycline. IDCases 2019, 18, e00600. [Google Scholar] [CrossRef] [PubMed]
- Tosun, M.N.; Demirel Zorba, N.N.; Yüceer, Y. The anti-quorum sensing and antitumor activity of Prunella vulgaris, Sambucus nigra, Calendula officinalis: Potential use in food industry: Potential use in food industry. J. Microbiol. Biotechnol. Food. Sci. 2021, 10, e2774. [Google Scholar]
- Prateeksha; Singh, B.R.; Shoeb, M.; Sharma, S.; Naqvi, A.H.; Gupta, V.K.; Singh, B.N. Scaffold of selenium nanovectors and honey phytochemicals for inhibition of Pseudomonas aeruginosa quorum sensing and biofilm formation. Front. Cell. Infect. Microbiol. 2017, 7, 93. [Google Scholar] [CrossRef] [PubMed] [Green Version]
- Lahiri, D.; Nag, M.; Dutta, B.; Mukherjee, I.; Ghosh, S.; Dey, A.; Ray, R.R. Catechin as the most efficient bioactive compound from Azadirachta indica with antibiofilm and anti-quorum sensing activities against dental biofilm: An in vitro and in silico study. Appl. Biochem. Biotechnol. 2021, 193, 1617–1630. [Google Scholar] [CrossRef] [PubMed]
- Gómez-Gómez, B.; Arregui, L.; Serrano, S.; Santos, A.; Pérez-Corona, M.T.; Madrid, Y. Selenium and tellurium-based nanoparticles as interfering factors on Quorum sensing-regulated processes: Violacein production and bacterial biofilm formation. Metallomics 2019, 11, 1104–1114. [Google Scholar] [CrossRef]
- Escobar-Ramírez, M.C.; Castañeda-Ovando, A.; Pérez-Escalante, E.; Rodríguez-Serrano, G.M.; Ramírez-Moreno, E.; Quintero-Lira, A.; Contreras-López, E.; Añorve-Morga, J.; Jaimez-Ordaz, J.; González-Olivares, L.G. Antimicrobial activity of Se-nanoparticles from bacterial biotransformation. Fermentation 2021, 7, 130. [Google Scholar] [CrossRef]
- Gnarpe, H.; Michaelsson, M.; Dreborg, S. The in vitro effect of ascorbic acid on the bacterial growth in urine. Acta Pathol. Microbiol. Scand. 1968, 74, 41–50. [Google Scholar] [CrossRef]
- Novak, J.S.; Fratamico, P.M. Evaluation of ascorbic acid as a quorum-sensing analogue to control growth, sporulation, and enterotoxin production in Clostridium perfringens. J. Food Sci. 2004, 69, FMS72–FMS78. [Google Scholar] [CrossRef]
- Hegerova, D.; Vesely, R.; Cihalova, K.; Kopel, P.; Milosavljevic, V.; Heger, Z.; Hynek, D.; Guran, R.; Vaculovicova, M.; Sedlacek, P.; et al. Antimicrobial agent based on selenium nanoparticles and carboxymethyl cellulose for the treatment of bacterial infections. J. Biomed. Nanotechnol. 2017, 13, 767–777. [Google Scholar] [CrossRef]
- Kondaparthi, P.; Flora, S.J.S.; Naqvi, S. Selenium nanoparticles: An insight on its pro-oxidant and antioxidant properties. Front. Nanosci. Nanotechnol. 2019, 6, 1–5. [Google Scholar] [CrossRef]
- Apak, R.; Özyürek, M.; Guclu, K.; Capanoglu, E. Antioxidant activity/capacity measurement: I. Classification, physico-chemical principles, mechanisms and electron transfer (ET)-based assays. J. Agric. Food. Chem. 2016, 64, 997–1027. [Google Scholar] [CrossRef] [PubMed]
- Ramoutar, R.R.; Brumaghim, J.L. Effects of inorganic selenium compounds on oxidative DNA damage. J. Inorg. Biochem. 2007, 101, 1028–1035. [Google Scholar] [CrossRef] [PubMed]
- Bhattacharjee, A.; Basu, A.; Bhattacharya, S. Selenium nanoparticles are less toxic than inorganic and organic selenium to mice in vivo. Nucleus 2019, 62, 259–268. [Google Scholar] [CrossRef]
- Vera, P.; Echegoyen, Y.; Canellas, E.; Nerín, C.; Palomo, M.; Madrid, Y.; Cámara, C. Nano selenium as antioxidant agent in a multilayer food packaging material. Anal. Bioanal. Chem. 2016, 408, 6659–6670. [Google Scholar] [CrossRef]
- Preethi, K.C.; Girija, K.; Ramadasan, K. Antioxidant potential of an extract of Calendula officinalis. Flowers in vitro. and in vivo. Pharm. Biol. 2006, 44, 691–697. [Google Scholar] [CrossRef] [Green Version]
- Bedlovičová, Z.; Imrich, S.; Matej, B.; Aneta, S. A Brief overview on antioxidant activity determination of silver nanoparticles. Molecules 2020, 25, 3191. [Google Scholar] [CrossRef] [PubMed]
- Torres, S.K.; Campos, V.L.; León, C.G.; Rodriguez-Llamazares, S.M.; Rojas, S.M.; Gonzalez, M.; Smith, C.; Mondaca, M.A. Biosynthesis of selenium nanoparticles by Pantoeaagglomerans and their antioxidant activity. J. Nanopart. Res. 2012, 14, 1236. [Google Scholar] [CrossRef]
- Zhai, X.; Zhang, C.; Zhao, G.; Stoll, S.; Ren, F.; Leng, X. Antioxidant capacities of the selenium nanoparticles stabilized by chitosan. J. Nanobiotechnol. 2017, 15, 4. [Google Scholar] [CrossRef] [Green Version]
- Alafeef, A.K.; Ariffin, F.; Zulkurnain, M. Organic selenium as antioxidant additive in mitigating acrylamide in coffee beans roasted via conventional and superheated steam. Foods 2020, 9, 1197. [Google Scholar] [CrossRef] [PubMed]
- Alipour, S.; Kalari, S.; HosseinMorowvat, M.; Sabahi, Z.; Dehshahri, A. Green synthesis of selenium nanoparticles by cyanobacterium Spirulina platensis (abdf2224): Cultivation condition quality controls. Biomed. Res. Int. 2021, 6635297. [Google Scholar]
- Wu, C.F.; Xu, X.M.; Zhu, Q.; Deng, M.C.; Feng, L.; Peng, J.; Yuan, J.P.; Wang, J.H. An effective method for the detoxification of cyanide-rich waste water by Bacillus sp. CN-22. Appl. Microbiol. Biotechnol. 2014, 98, 3801–3807. [Google Scholar] [CrossRef]
- Al Laham, S.A.; Al Fadel, F.M. Antibacterial activity of various plants extracts against antibiotic-resistant Aeromonas hydrophila. Jundishapur, J. Microbiol. 2014, 7, e11370. [Google Scholar] [CrossRef] [Green Version]
- Re, R.; Pellegrini, N.; Proteggente, A.; Pannala, A.; Yang, M.; Rice-Evans, C. Antioxidant activity applying an improved ABTS radical cation decolorization assay. Free. Radic. Biol. Med. 1999, 26, 1231–1237. [Google Scholar] [CrossRef]
- Flores, D.R.; Casados, L.E.; Velasco, S.F.; Ramírez, A.C.; Velázquez, G. Comparative study of composition, antioxidant and antimicrobial activity of two adult edible insects from Tenebrionidae family. BMC Chem. 2020, 14, 55. [Google Scholar] [CrossRef] [PubMed]
- Oyaizu, M. Studies on products of browning reactions: Antioxidative activities of product of browning reaction prepared from glucosamine. Jap. J. Nutr. 1986, 44, 307–315. [Google Scholar] [CrossRef] [Green Version]
- Desmarchelier, C.; Bermudez, M.J.N.; Coussio, J.; Ciccia, G.; Boveris, A. Antioxidant and prooxidant activities in aqueous extract of Argentine plants. Int. J. Pharmacogn. 1997, 35, 116–120. [Google Scholar] [CrossRef]

Publisher’s Note: MDPI stays neutral with regard to jurisdictional claims in published maps and institutional affiliations. |
© 2021 by the authors. Licensee MDPI, Basel, Switzerland. This article is an open access article distributed under the terms and conditions of the Creative Commons Attribution (CC BY) license (https://creativecommons.org/licenses/by/4.0/).
Share and Cite
Hernández-Díaz, J.A.; Garza-García, J.J.; León-Morales, J.M.; Zamudio-Ojeda, A.; Arratia-Quijada, J.; Velázquez-Juárez, G.; López-Velázquez, J.C.; García-Morales, S. Antibacterial Activity of Biosynthesized Selenium Nanoparticles Using Extracts of Calendula officinalis against Potentially Clinical Bacterial Strains. Molecules 2021, 26, 5929. https://doi.org/10.3390/molecules26195929
Hernández-Díaz JA, Garza-García JJ, León-Morales JM, Zamudio-Ojeda A, Arratia-Quijada J, Velázquez-Juárez G, López-Velázquez JC, García-Morales S. Antibacterial Activity of Biosynthesized Selenium Nanoparticles Using Extracts of Calendula officinalis against Potentially Clinical Bacterial Strains. Molecules. 2021; 26(19):5929. https://doi.org/10.3390/molecules26195929
Chicago/Turabian StyleHernández-Díaz, José A, Jorge JO Garza-García, Janet M León-Morales, Adalberto Zamudio-Ojeda, Jenny Arratia-Quijada, Gilberto Velázquez-Juárez, Julio C López-Velázquez, and Soledad García-Morales. 2021. "Antibacterial Activity of Biosynthesized Selenium Nanoparticles Using Extracts of Calendula officinalis against Potentially Clinical Bacterial Strains" Molecules 26, no. 19: 5929. https://doi.org/10.3390/molecules26195929
APA StyleHernández-Díaz, J. A., Garza-García, J. J., León-Morales, J. M., Zamudio-Ojeda, A., Arratia-Quijada, J., Velázquez-Juárez, G., López-Velázquez, J. C., & García-Morales, S. (2021). Antibacterial Activity of Biosynthesized Selenium Nanoparticles Using Extracts of Calendula officinalis against Potentially Clinical Bacterial Strains. Molecules, 26(19), 5929. https://doi.org/10.3390/molecules26195929

